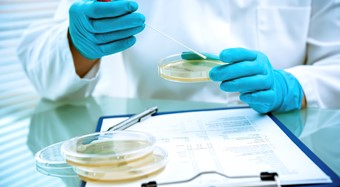
从科创板制度中的知识产权问题探讨初创企业知识产权构建策略

Awards

Ranked PRC Firm in IP (Contentious) - Legal 500 2024

Notable Firm - Benchmark Litigation Asia Pacific 2024

Ranked PRC Firm in Trade Mark & Patent Disputes - Managing IP : IP STARS 2024